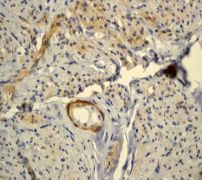

> Antigen, Antibodies, ELISA, Western Blot > Primary Antibody > Monoclonal Antibodies > Filamin-A Antibody Phospho (pS1458)Brand |
Leading Biology | Catalog Number |
APR15961G |
Product Type |
Monoclonal Antibodies | Field of Research |
|
Product Overview |
We constantly strive to ensure we provide our customers with the best antibodies. As a result of this work we offer this antibody in purified format.
We are in the process of updating our datasheets. If you have any questions regarding this update, please feel free to contact our technical support team.
This product is a high quality Filamin-A antibody Phospho (pS1458).
|
||
Molecular Weight |
280739 Da
|
||
Cellular Localization |
Antigen Cellular Localization:
Cytoplasm, cell cortex. Cytoplasm, cytoskeleton
|
||
Host |
Rabbit
|
||
Species Reactivity |
Human
|
||
Target |
A phospho specific peptide corresponding to residues surrounding serine 1458 of human Filamin A was used as an immunogen. This antibody detects Filamin A phosphorylated at serine 1458.
|
||
Clone |
EP2309Y
|
||
Symbol |
FLN, FLN1
|
||
GeneID |
|||
UniProt ID |
|||
Function |
Promotes orthogonal branching of actin filaments and links actin filaments to membrane glycoproteins. Anchors various transmembrane proteins to the actin cytoskeleton and serves as a scaffold for a wide range of cytoplasmic signaling proteins. Interaction with FLNA may allow neuroblast migration from the ventricular zone into the cortical plate. Tethers cell surface- localized furin, modulates its rate of internalization and directs its intracellular trafficking (By similarity). Involved in ciliogenesis.
|
||
Summary |
Filamins are a family of high molecular mass cytoskeletal proteins that organize filamentous actin in networks and stress fibers. Recently it has become clear that filamins anchor various transmembrane proteins to the actin cytoskeleton and provide a scaffold for a wide range of cytoplasmic signaling proteins (1). Actin-binding protein (Filamin A) is a ubiquitous dimeric actin cross-linking phosphoprotein of peripheral cytoplasm, where it promotes orthogonal branching of actin filaments and links actin filaments to membrane glycoproteins (2). The actin-binding domain is near the amino-terminus of the subunit where the amino acid sequence is similar to other actin filament binding proteins, including alpha-actinin, beta-spectrin, dystrophin, and Dictyostelium abp-120. Detection of Filamin A /Fh1 proteins suggests that these presenilin-interacting proteins may be involved in the development of Alzheimer's disease and that interactions between presenilins and Filamin A /Fh1 may be functionally significant (3).
|
||
Form |
50 mM Tris-Glycine (pH 7.4), 0.15 M NaCl, 40% Glycerol, 0.01% sodium azide and 0.05% BSA. |
||
Storage & Stability |
Store at +4°C short term. For long-term storage, aliquot and store at -20°C or below. Stable for 12 months at -20°C. Avoid repeated freeze-thaw cycles.
|
||
Applications |
WB, IHC
|
||
Dilution |
WB~~1:5000~20000
IHC~~1:50~100
|
||
Synonyms |
Filamin-A, FLN-A, Actin-binding protein 280, ABP-280, Alpha-filamin, Endothelial actin-binding protein, Filamin-1, Non-muscle filamin, FLNA, FLN, FLN1
|
||
Images |

A. Western blot analysis on HeLa cell lysates using anti-Phospho-Filamin A (pS1458) RabMAb (Cat. APR15961G), 1:5000 dilution. Cells were either (A) untreated (B) treated with AP 
B. Immunohistochemical analysis of paraffin-embedded human stomach using Phospho-specific anti-Filamin A RabMAb (Cat. APR15961G)
C. Immunohistochemical analysis of paraffin-embedded human uterus using Phospho-specific anti-Filamin A RabMAb (Cat. APR15961G). |
||
Specification |
|||
Quantity |
|
||
| Select | Brand | Catalog No. | Product Name | Pack Size | Type | Field of Research | Specification | Quantity | Price(USD) | |
| 1 | Leading Biology | APG02467G | CCK4 / PTK7 Antibody (clone 4F9) | 50 μl | Monoclonal Antibodies |
|
$495.00 | Add Ask | ||
| 2 | Leading Biology | AMM04683G | GALT Antibody (clone 4C11) | 50 μg | Monoclonal Antibodies |
|
$545.00 | Add Ask | ||
| 3 | Leading Biology | AMM01402G | Vimentin (Mesenchymal Cell Marker) Antibody - With BSA and Azide | 50 ug | Monoclonal Antibodies |
|
$395.00 | Add Ask | ||
| 4 | Leading Biology | APR08280G | LTA4H / LTA4 Antibody (clone 9G8) | 50 μl | Monoclonal Antibodies |
|
$495.00 | Add Ask | ||
| 5 | Leading Biology | AMM00172G | CD1a / HTA1 (Mature Langerhans Cells Marker) Antibody - With BSA and Azide | 50 ug | Monoclonal Antibodies |
|
$395.00 | Add Ask | ||
| 6 | Leading Biology | AMM05750G | CEBPA Antibody | 100 μl | Monoclonal Antibodies |
|
$545.00 | Add Ask |
 Leading Biology Inc.
2600 Hilltop DR, Building G, B Suite C138
Richmond, CA, 94806
Tel: 1-661-524(LBI)-0262
Email: info@leadingbiology.com
Leading Biology Inc.
2600 Hilltop DR, Building G, B Suite C138
Richmond, CA, 94806
Tel: 1-661-524(LBI)-0262
Email: info@leadingbiology.com
Complete this form and click send to ask us a question, request a quote or simply say hello.

You have 0 item in your cart

You have 0 item in your inquiry list
